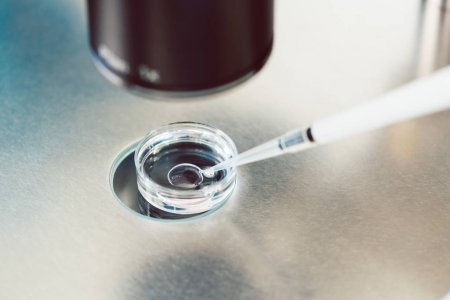

Vivo представила чип V1+, предназначенный для обработки изображений на смартфонах. Устройство было разработано совместно с компанией MediaTek. Специалисты отмечают, что новинка делает Vivo единственным производителем смартфонов, способным устанавливать в устройства собственные процессоры для камер.

Представленный чип V1+ — улучшенная версия прошлогоднего V1. На этот раз Vivo объединилась с экспертами из MediaTek. В результате совместной работы V1+ получил нативную поддержу процессора MediaTek Dimensity 9000.
На презентации представители компании сообщили, что Vivo V1+ поможет пользователям делать качественные снимки в экстремально темных условиях. Алгоритмы ночного режима съемки отрабатывают даже при уровне освещения менее 1 люкса. Также на 16% увеличили общую яркость фотографий и на 12% улучшили точность баланса белого. Все сравнения проводились с прошлогодним чипом V1.
Обзор Vivo Y21 2021 — это вам НЕ ДЕШЁВКА!
V1+ получил поддержку технологии Zeiss Natural Color, обеспечивающую более точную цветопередачу. Также сообщили, что чип может выступать в роли сопроцессора и разгружать систему во время выполнения «тяжелых» задач. Так V1+ поможет запускать больше игр в 60 и 120 FPS. На презентации отметили, что такое применение чипа поможет на 10% снизить энергопотребление.
Первым поддержку V1+ получит смартфон Vivo X80, оснащенный продвинутой системой камер. Официально устройство презентуют на следующей неделе.
Источник: habr.com
Как удалить Vivo аккаунт с компьютера и планшета


Vivo аккаунт – это учетная запись, которую создают пользователи мобильных устройств Vivo для получения доступа к различным функциям и сервисам. Она позволяет синхронизировать данные, сохранять контакты, резервировать информацию и многое другое. Но иногда пользователи решают удалить свой Vivo аккаунт. В этой статье мы расскажем, как это сделать с компьютера и планшета.
Как удалить Vivo аккаунт с компьютера?
Шаг 1: Откройте официальный сайт Vivo
Перейдите на официальный сайт Vivo и войдите в свой аккаунт с помощью логина и пароля.
Шаг 2: Выберите ”Настройки аккаунта”
После входа в свой аккаунт выберите ”Настройки аккаунта” в верхнем правом углу экрана.
Шаг 3: Удалите аккаунт
Прокрутите страницу вниз и найдите кнопку ”Удалить аккаунт”. Нажмите на нее и подтвердите свое решение. Ваш Vivo аккаунт будет удален.
Обзор VIVO Y31 — удивительно бюджетно для VIVO и удивительно приятно для 200$.
Как удалить Vivo аккаунт с планшета?
Шаг 1: Откройте настройки планшета
Откройте настройки планшета и найдите раздел ”Аккаунты”.
Шаг 2: Выберите Vivo аккаунт
Выберите Vivo аккаунт из списка аккаунтов, которые связаны с вашим планшетом.
Шаг 3: Удалите аккаунт
Нажмите на кнопку ”Удалить аккаунт” и подтвердите свое решение. Ваш Vivo аккаунт будет удален с планшета.
Вывод
Удаление Vivo аккаунта может быть необходимо в различных ситуациях. Следуйте нашим инструкциям, чтобы удалить свой аккаунт с компьютера и планшета без проблем.
Предыдущая запись Как скачать с телефона Vivo на компьютер: пошаговая инструкция
Следующая запись Как поменять шрифт на телефоне Vivo: пошаговая инструкция

Владислав Жипитенко
Я уже более 7 лет занимаюсь продвижением бизнесов в социальных сетях. В своем блоге я делюсь опытом, знаниями и полезными советами, которые помогут вам повысить эффективность вашего SMM и достичь успеха в Интернете. Буду рад поделиться с вами своими знаниями и опытом работы в сфере социальных медиа!
Оцените автора

Источник: yappyblog.ru
В чем разница между in vivo и in vitro?
Медицинские статьи для широкой аудитории часто используют термины “ in vitro ” и “ in vivo ” для описания исследований. С латинского in vitro – переводится “в стекле”, а in vivo переводится как “в жизни”.
Определения
Термин in vitro указывает, что медицинские процедуры, тесты и эксперименты исследователи проводят вне живого организма. Исследование in vitro проводится в контролируемой среде, такой как пробирка или чашка Петри.
Термин in vivo указывает, что исследование проводится в естественных условиях. Это относится к тестам, экспериментам и процедурам, которые ученые выполняют на живом организме, таком как человек, лабораторное животное или растение.
Примеры
Исследователи используют методики in vivo и in vitro для углубления наших знаний о болезнях и человеческом теле. В научных исследованиях ученые могут проверить гипотезу, используя один или оба этих метода.
В пробирке
Тестирование in vitro происходит в лаборатории и обычно включает в себя изучение микроорганизмов, клеток человека или животных в культуре. Эта методология позволяет ученым оценивать различные биологические явления в конкретных клетках без отвлекающих факторов и потенциальных запутывающих переменных, присутствующих в целых организмах.
Тестирование in vitro – это простая методология исследования. Ученые могут проводить детальные анализы и изучать биологические эффекты у большего числа субъектов in vitro, чем в экспериментах на животных или людях.
Однако, хотя чашки Петри и пробирки обеспечивают контролируемую среду для испытаний in vitro, они не могут воспроизвести условия, которые происходят внутри живого организма.
В результате, интерпретировать данные in vitro необходимо с осторожностью, так как полученные результаты не могут предсказать реакцию живого существа.
Некоторые примеры тестирования in vitro включают фармацевтическое тестирование и лечение бесплодия.
Фармацевтические испытания
Новые лекарственные препараты проходят тестирование in vitro, прежде чем начинаются клинические испытания. Во время доклинического испытания in vitro исследователи подвергают клетки-мишени воздействию нового препарата и контролируют его действие. Тестирование in vitro особенно полезно для определения того, обладает ли новый препарат токсическими и канцерогенными эффектами.
В исследовании 2018 года ученые из Италии использовали тестирование in vitro для мониторинга токсического действия наночастиц оксида молибдена – многообещающего нового метода лечения рака. Наночастицы – это небольшие или ультрадисперсные частицы, размер которых обычно составляет 1-100 нанометров.
Авторы одного из исследований 2017 года определили персонализированные методы лечения рака с использованием моделей in vitro.
В ходе исследования ученые собрали клетки из двух опухолей матки и двух опухолей толстой кишки. Ученые проанализировали опухолевые клетки с помощью высокопроизводительного скрининга лекарственных средств, который сочетает в себе биологию, робототехнику и обработку данных для тестирования тысяч различных биологических соединений на одной клетке-мишени.
В результате анализа были выявлены эффективные лекарственные средства и их комбинации, специфичные для каждого образца клеток.
Лечение бесплодия
Экстракорпоральное оплодотворение (ЭКО) – это вид лечения бесплодия, при котором оплодотворение происходит в лаборатории, а не внутри организма.
ЭКО включает в себя извлечение одной или нескольких яйцеклеток из яичника и помещение их в чашку Петри с донорской спермой. Оплодотворение обычно происходит в течение 3-5 дней . Затем врач имплантирует полученные эмбрионы в матку.
В естественных условиях
Несмотря на положительные доклинические результаты, около 30% лекарственных препаратов терпят неудачу в клинических испытаниях на людях из-за возникновения неблагоприятных побочных эффектов. Дополнительные 60% не дают желаемого эффекта.
Тестирование in vivo, особенно в клинических испытаниях, является жизненно важным аспектом медицинских исследований в целом. Исследования in vivo дают ценную информацию о влиянии конкретного вещества или прогрессировании заболевания на весь живой организм. Основными видами тестов in vivo являются исследования на животных и клинические испытания.
Исследования на животных
Ученые используют исследования на животных для выявления механизмов, лежащих в основе различных процессов заболевания, и для оценки безопасности новых методов лечения.
Исследования на животных служат своего рода промежуточным звеном между экспериментами in vitro и испытаниями на людях. Большинство исследований на животных используют лабораторных мышей или крыс, которые почти генетически идентичны. В результате исследователи могут отслеживать различные биологические эффекты внутри сложных организмов.
Тестирование генетически схожих объектов в лабораторных условиях обеспечивает такую степень контроля, которая отсутствует в клинических испытаниях.
Проведение клинических испытаний
Если препарат окажется безопасным и эффективным в исследованиях in vitro и на животных, эксперты оценят его действие на людях с помощью клинических испытаний. Исследователи зачастую сравнивают эффекты новых лекарственных препаратов с эффектами плацебо. Многие считают рандомизированные контролируемые исследования золотым стандартом фармацевтического тестирования. Все исследования должны включать рандомизацию и контроль.
При рандомизации исследователи случайным образом распределяют участников либо в группу лечения, либо в группу плацебо.
При контрольном исследовании ученые сравнивают результаты участника, получившего новое лекарственное средство или вмешательство, с результатами участника контрольной группы. Участники контрольной группы получают альтернативное лечение, например плацебо или старую форму нового препарата.
Исследователи могут скрывать информацию, которая может повлиять на участника эксперимента, до тех пор, пока испытание не закончится.
Слепое исследование может включать распределение препарата и плацебо в одинаковых капсулах, чтобы участники не могли сказать, в какой группе лечения они находятся.
Заключение
Исследования in vitro и in vivo дают ценную информацию для всех этапов биомедицинских исследований. Ученые часто используют методы in vitro для фундаментальных исследований, чтобы исследовать лекарственные взаимодействия и патологические процессы на клеточном уровне.
Исследования in vivo расширяют данные исследований in vitro путем мониторинга биологических реакций живых организмов.

Врач ультразвуковой диагностики АО “СЗЦДМ” (г. Санкт-Петербург)
Учредитель сетевого издания Medical Insider, главный редактор и автор статей.
Источник: medicalinsider.ru
